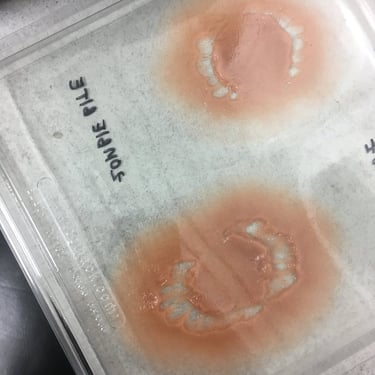

- YASUS EFECTUS -
Heart
Material : Silicon Plat gel 10
Moulds by: Twilight Creations
Running pieces: Lala Rodriguez
Beating system: Lala Rodriguez
Painting and Application: Lala Rodriguez
Ripped heart wound
Material : Bondo
Mould making: Zombie bite from Twilight Creations SHOP
Running pieces: Lala Rodriguez
Painting and Application: Lala Rodriguez
Place: Berlin - Germany 2019